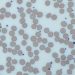
Long-term dual antiplatelet therapy does not increase mortality risk

1. Compared to intravenous ertapenem, oral tebipenem pivoxil hydrobromide was non-inferior in the treatment of complicated urinary tract infection and acute pyelonephritis.
2. Oral tebipenem pivoxil hydrobromide had a similar safety profile as compared to intravenous ertapenem.
Evidence Rating Level: 1 (Excellent)
Study Rundown: Currently, complicated urinary tract infections (including acute pyelonephritis), are typically treated with hospitalization and IV therapy for antibiotic-resistant uropathogens. Therefore, there is a need for effective oral treatment options for patients with complicated UTIs due to antimicrobial-resistant pathogens, and oral tebipenem pivoxil hydrobromide has been proposed to be a broad-spectrum oral medication against multidrug-resistant gram-negative pathogens. However, there is a gap in knowledge as to understanding oral tebipenem pivoxil hydrobromide as compared with IV ertapenem in hospitalized patients with complicated UTIs or acute pyelonephritis. This study found that oral tebipenem pivoxil hydrobromide was non-inferior to IV ertapenem in patients with complicated UTIs or acute pyelonephritis and had a similar safety profile. This study was limited by factors such as the mandated 7-10 day course of antibiotic therapy, as this might reflect the standard of care for complicated UTIs in the US, as well as variability in the specific strains and resistance mechanisms of the pathogens studied. Nevertheless, these study’s findings are significant, as they demonstrate that oral tebipenem pivoxil hydrobromide is a viable option for the treatment of complicated UTIs and acute pyelonephritis due to antibiotic-resistant uropathogens.
Click to read the study in NEJM
Relevant Reading: Once-Daily Plazomicin for Complicated Urinary Tract Infections
In-Depth [randomized control trial]: This randomized control trial studied patients at 95 sites throughout Central and Eastern Europe, South Africa, and the United States. Patients who were hospitalized, at least 18 years of age, and had received a diagnosis of complicated UTI or acute pyelonephritis were eligible for the study. Patients who had confirmed carbapenem-resistant pathogen, creatinine clearance of 30ml per minute or less, septic shock, severe hepatic impairment, pregnancy, immunocompromised, or hypersensitivity to any beta-lactam antibiotic were excluded from the study. The primary outcome measured was an overall response in the microbiologic intention-to-treat population at the test-of-cure visit (on day 19), with clinical cure defined as complete resolution or clinically significant alleviation of baseline signs and symptoms of complicated UTI or acute pyelonephritis. Outcomes in the primary analysis were assessed via Cochran-Mantel-Haenszel weighted Miettinen and Nurminen method stratified according to age. Based on the analysis, the overall response was seen in 58.8% of patients who received oral tebipenem pivoxil hydrobromide, as compared with 61.6% who received ertapenem (95% Confidence Interval [CI], -9.7 to 3.2). Clinical cure at the test-of-cure visit was seen in 93.1% of patients who received oral tebipenem pivoxil hydrobromide and in 93.6% of patients who received ertapenem (95% CI, -4.0 to 2.8). Adverse events were observed in 25.7% of patients who received oral tebipenem pivoxil hydrobromide and in 25.6% of patients who received ertapenem, with mild diarrhea and headache as the most common events, while no serious adverse events were reported. Overall, this study demonstrated that oral tebipenem pivoxil hydrobromide is non-inferior to IV ertapenem and can serve as a viable option for the treatment of complicated UTIs and acute pyelonephritis.
Image: PD
©2022 2 Minute Medicine, Inc. All rights reserved. No works may be reproduced without expressed written consent from 2 Minute Medicine, Inc. Inquire about licensing here. No article should be construed as medical advice and is not intended as such by the authors or by 2 Minute Medicine, Inc.